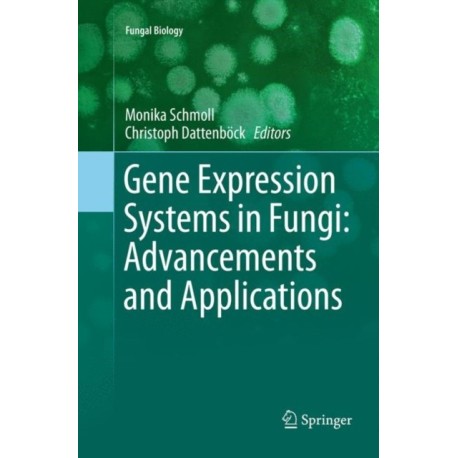
Gene Expression Systems in Fungi: Advancements and Applications

Kurv
Vare
varer
(tom)
Ingen varer
Fastlægges senere
Forsendelse
0,- kr
I alt
Gene Expression Systems in Fungi: Advancements and Applications
(Bog, Paperback / softback, Engelsk)
Beskrivelse
Industrial application and exploitation of the metabolic capacities of fungi requires highly productive and robust gene expression systems, which can be achieved by selection of appropriate species and strain improvement.
Læsernes anmeldelser (0)
Alle detaljer
| Forlag | Springer International Publishing AG |
| Type | Bog |
| Format | Paperback / softback |
| Sprog | Engelsk |
| Udgave | Softcover reprint of the original 1st ed. 2016 |
| Udgivelsesdato | 25-04-2018 |
| Første udgivelsesår | 2018 |
| Serie | Fungal Biology |
| Illustrationer | 19 Illustrations, color; 19 Illustrations, black and white |
| Fagredaktør | Monika Schmoll, Christoph Dattenbock |
| Originalsprog | Switzerland |
| Sideantal | 499 |
| Indbinding | Paperback / softback |
| Forlag | Springer International Publishing AG |
| Sideoplysninger | 499 pages, 19 Illustrations, color; 19 Illustrations, black and white |
| Mål | 235 x 155 |
| ISBN-13 / EAN-13 | 9783319802459 |


